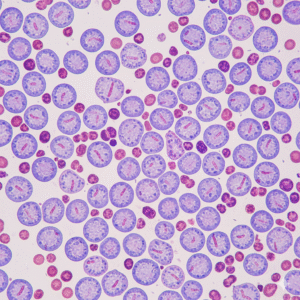
Acute Leukemia Comprehensive Panel Flowcytometry

Uncategorized
Showing 10–18 of 350 results
-
Uncategorized
Activated Partial Thromboplastin Time(APTT)
₹510.00Original price was: ₹510.00.₹440.00Current price is: ₹440.00. -
Uncategorized
Activated Protein C-Resistance (APCR)
₹5,000.00Original price was: ₹5,000.00.₹4,590.00Current price is: ₹4,590.00. -
Uncategorized
Acute Leukaemia Flow+Karyotyping
₹25,000.00Original price was: ₹25,000.00.₹21,000.00Current price is: ₹21,000.00. -
Uncategorized
Acute Leukaemia Karyo Typing
₹6,000.00Original price was: ₹6,000.00.₹5,900.00Current price is: ₹5,900.00. -
Uncategorized
Acute Leukemia Comprehensive Panel Flowcytometry
₹15,000.00Original price was: ₹15,000.00.₹12,500.00Current price is: ₹12,500.00. -
Uncategorized
Adenosine Deaminase Fluid (ADA)
₹610.00Original price was: ₹610.00.₹488.00Current price is: ₹488.00. -
Uncategorized
Adenosine Deaminase Serum (ADA)
₹1,400.00Original price was: ₹1,400.00.₹619.00Current price is: ₹619.00. -
Uncategorized
Adenovirus Qualitative PCR
₹5,700.00Original price was: ₹5,700.00.₹5,200.00Current price is: ₹5,200.00. -
Uncategorized
Adreno Corticotrophic Hormone (ACTH)
₹2,550.00Original price was: ₹2,550.00.₹1,800.00Current price is: ₹1,800.00.